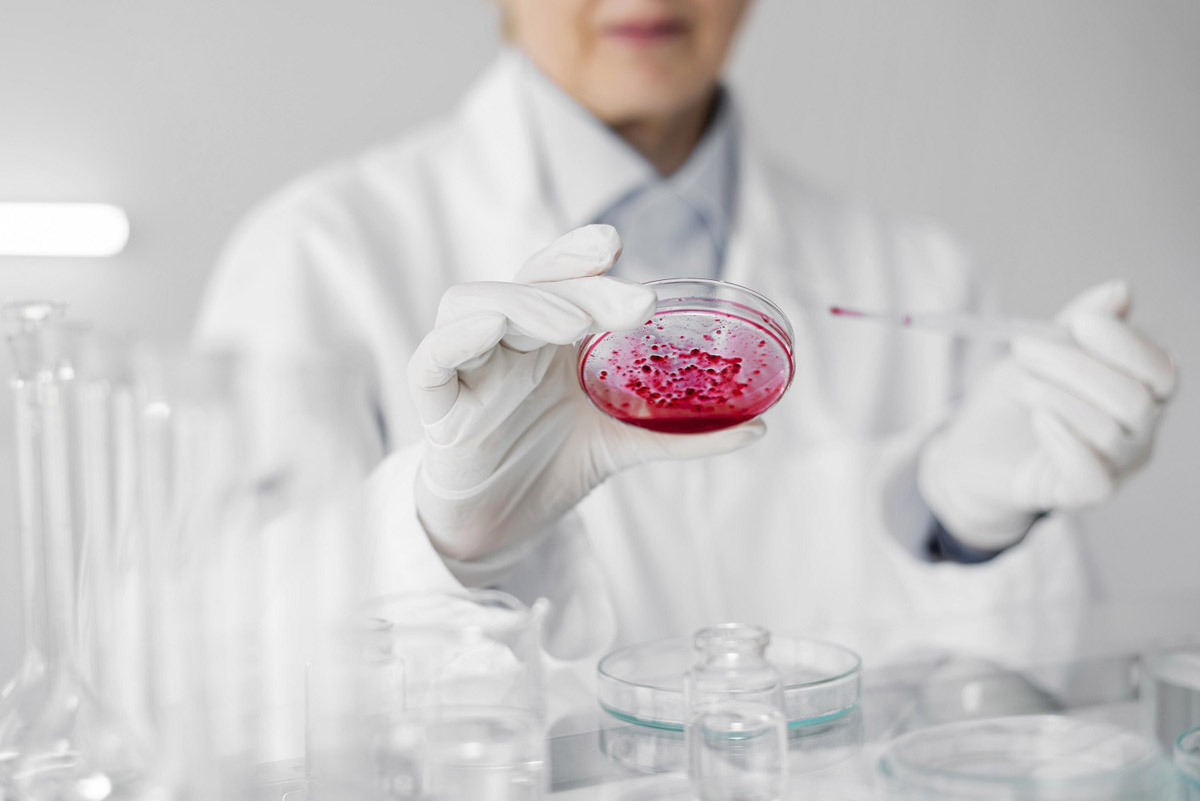

врач акушер-гинеколог высшей категории, специалист по репродуктологии, клинической гемостазиологии, интегративной и антивозрастной медицине.


ДЛЯ ВРАЧЕЙ
ПО АНТИВОЗРАСТНОЙ
МЕДИЦИНЕ
практикующих международных экспертов
Антивозрастная медицина находится на пороге фундаментальной смены парадигмы. Еще десятилетие назад основными инструментами врача anti-age были гормональная заместительная терапия, ретиноиды и лазерные «шлифовки» — подходы, направленные на симптоматическую коррекцию уже проявившихся дефектов. Сегодня эпицентр дискуссий сместился в сторону регенерации тканей и управления клеточным гомеостазом.
Однако на пути внедрения этих технологий в рутинную практику существует серьезное препятствие: колоссальный разрыв между агрессивным маркетингом биотех-стартапов, обещающих «вечную молодость» с помощью одной инъекции, и скептицизмом доказательной медицины. Для врача, практикующего антивозрастную медицину, критически важно отделить зерна от плевел: где заканчиваются маркетинговые обещания и начинаются клинические результаты, подтвержденные мета-анализами и консенсус-документами?
В этой статье мы предлагаем взглянуть на регенеративные технологии не через призму «волшебной таблетки», а через инструментарий профессионала. Мы разберем, какие инновационные методы сегодня имеют прочную научную базу, а какие находятся в стадии гипотез, и как построить безопасную и эффективную стратегию восстановления клеток, опираясь на принципы доказательной медицины.

что известно и что предстоит узнать
Фундаментальные основы: мишени для регенерации
Прежде чем говорить о методах, необходимо определить мишени. Для anti-age специалиста старение — это не набор изолированных болезней, а ускоренная потеря функционального резерва организма. Согласно концепции Hallmarks of Aging (признаки старения), опубликованной в журнале Cell и обновленной в 2023 году, именно истощение пула стволовых клеток и нарушение межклеточной коммуникации являются конечными звеньями, запускающими каскад инволютивных изменений.
В клинической практике мы часто путаем понятия «регенерация» и «репарация». Репарация — это заживление дефекта с образованием рубца или фиброза. Это то, к чему стремится традиционная хирургия и терапия. Регенерация же подразумевает восстановление исходной архитектуры ткани и функциональности ниши стволовых клеток.
Для anti-age врача принципиально важно понимать: истинное омоложение возможно только тогда, когда мы восстанавливаем микроокружение, позволяющее собственным прогениторным клеткам делиться и дифференцироваться. Без этого даже самые современные биоматериалы будут работать по принципу «заплатки», а не омоложения.

Клеточные технологии: реалии применения
Мезенхимальные стромальные клетки (МСК): от замещения к паракринной парадигме
Рынок стволовых клеток долгое время эксплуатировал идею «замещения»: ввел клетки — они заменили погибшие нейроны или хондроциты. Сегодня наука отвергает эту упрощенную модель.
Современные исследования подтверждают, что терапевтический эффект МСК (мезенхимальных стромальных клеток) обусловлен паракринной парадигмой. Клетки работают как «лекарственный магазин», выделяя секрет, богатый факторами роста, цитокинами и экзосомами. Они модулируют иммунный ответ, подавляют воспаление и индуцируют хемотаксис собственных клеток-предшественников.
Мета-анализ 2024 года, опубликованный в Stem Cells Translational Medicine, оценивающий эффективность МСК при остеоартрите коленного сустава (более 1500 пациентов), показал статистически значимое улучшение по шкалам WOMAC и VAS через 6–12 месяцев. Однако результаты в реальной практике часто скромнее, чем в пилотных исследованиях. Причина — гетерогенность продуктов.
Для практикующего врача критически важен вопрос: аутологичные или аллогенные клетки использовать?
Данные свидетельствуют, что собственные МСК пациента старше 60 лет имеют сниженный пролиферативный и секреторный потенциал. Их культивирование часто дает малый выход клеток с признаками сенесценции. Аллогенные (донорские) МСК, особенно полученные из пуповинного канатика или жировой ткани молодых доноров, демонстрируют более выраженную иммуномодулирующую активность, что делает их предпочтительным выбором в anti-age стратегиях.

CAR-T и сенесцентные клетки (Senolytics 2.0)
Одной из самых обсуждаемых инноваций последних двух лет стало применение CAR-T-терапии (химерные антигенные рецепторы) для элиминации сенесцентных клеток.
В доклинических исследованиях (мышиные модели) использование CAR-T, нацеленных на антиген uPAR, привело к увеличению продолжительности жизни, улучшению метаболического профиля и снижению признаков атеросклероза.
На сегодняшний день это остается областью доклинических исследований и ранних фаз РКИ. Основные барьерами являются:
токсичность — риск цитокинового шторма и синдрома высвобождения цитокинов (CRS), характерный для CAR-T-терапии в онкологии;
селективность — необходимость поиска уникального антигена, экспрессируемого именно сенесцентными клетками, без поражения здоровых;
этические и регуляторные вопросы — в РФ и большинстве стран Европы такая терапия пока недоступна в рамках антивозрастной медицины.
Экзосомы и секретом: новая фармакология
Если клеточная терапия вызывает много вопросов у регуляторов и пациентов из-за рисков неконтролируемого роста, то биорепаративные технологии на основе экзосом становятся "золотой серединой".
Экзосомы — это внеклеточные везикулы размером 30–150 нм, осуществляющие горизонтальный перенос мРНК, микроРНК и белков между клетками. Их главное преимущество перед целыми клетками — низкая иммуногенность и возможность стандартизации.

5 точек приложения для врача,
работающего с костной тканью
Клиническое применение в anti-age практике
1. Эстетическая медицина и трихология
Экзосомы из МСК жировой ткани или пуповинного канатика активно применяются для омоложения кожи и лечения андрогенной алопеции. В отличие от PRP терапии, которая лишь высвобождает факторы роста из тромбоцитов пациента (сниженные у возрастных пациентов), экзосомы несут регуляторные РНК, способные "перепрограммировать" фибробласты и кератиноциты. Хотя крупных РКИ (рандомизированных клинических исследований) по косметологическим применениям пока недостаточно, имеющиеся кейс-серии демонстрируют утолщение дермы и увеличение терминальных волос на 20–30% через 12 недель.
2. Висцеральная медицина
Наиболее перспективно применение экзосом при фиброзах. Фиброз печени или легких — это конечная стадия хронического воспаления, ведущая к утрате функции органа. Доклинические исследования показывают, что экзосомы МСК способны ингибировать трансдифференцировку фибробластов в миофибробласты, тормозя фиброз. Для anti-age врача это ключ к функциональному омоложению органов, не требующий агрессивной хирургии.
Критический взгляд: проблема стандартизации
Главная проблема, с которой сталкивается практикующий врач, — отсутствие единых протоколов. Методы очистки (ультрацентрифугирование, экструзия или хроматография) определяют конечный продукт. Регуляторный статус экзосом остается "серой зоной": в РФ они чаще всего проходят как "косметические средства" или "биологически активные добавки", но не как лекарственные препараты, что требует от врача повышенной ответственности за качество вводимого материала.

Биоматериалы и тканевая инженерия
Третий столп регенеративной медицины — это создание каркасов, имитирующих внеклеточный матрикс (ECM).
Гидрогели и 3D-культивирование
Современные протоколы культивирования клеток все чаще используют 3D-гидрогели. В условиях трехмерного пространства МСК сохраняют более высокий паракринный потенциал по сравнению с монослойным культивированием. Для врача это важно, поскольку некоторые коммерческие продукты предлагают "клетки в физрастворе", что снижает их выживаемость после инъекции.
Децеллюляризированный матрикс
Одним из наиболее изученных материалов в зарубежной практике является dHACM (децеллюляризированный матрикс амниотической мембраны). В отличие от простых филлеров, этот биоматериал содержит нативные факторы роста и цитокины, которые служат хемоаттрактантами для собственных стволовых клеток пациента. Это пример так называемой "in-situ регенерации" — когда мы не вводим чужие клетки, а создаем условия для миграции своих.
Биопечать органов: между реальностью и футуризмом
Технология 3D-биопринтинга активно развивается. На сегодняшний день в клинической практике (преимущественно в рамках экспериментов) применяются биочернила для замещения дефектов пародонта, реконструкции хряща и даже фрагментов щитовидной железы. Однако говорить о полноценной печати функциональных органов для замены утраченных функций в рутинной anti-age практике пока преждевременно.

Персонализация и оценка результатов
Для врача, который обучает или практикует антивозрастную медицину, ключевой вопрос звучит так: "Как измерить результат?" Переход от субъективных ощущений пациента к объективным биомаркерам старения — это то, что отличает доказательный anti-age подход от эзотерики.
Биомаркеры старения как конечные точки
Современные протоколы оценки эффективности регенерации тканей должны включать не только МРТ сустава или фото кожи, но и анализ эпигенетического возраста.
Эпигенетические часы. Исследования с применением МСК у пациентов с остеоартритом и сахарным диабетом 2 типа показали, что через 3–6 месяцев после введения наблюдается тенденция к снижению биологического возраста, измеренного по метилированию ДНК.
Длина теломер. Хотя этот маркер более инертен, существуют данные, что терапия даназолом при теломеропатиях (синдром Dyskeratosis congenita) приводит к удлинению теломер. Для anti-age медицины это демонстрирует принципиальную возможность фармакологического воздействия на этот механизм.

Протоколы комбинированной терапии
Клинические наблюдения и данные зарубежных исследований свидетельствуют о том, что эффективность регенеративных технологий напрямую зависит от исходного состояния микроокружения. Введение мезенхимальных стромальных клеток (МСК) и экзосом на фоне высокого уровня окислительного стресса и хронического вялотекущего воспаления является патогенетически необоснованным и не приводит к ожидаемому клиническому результату.
Эффективная anti-age стратегия включает этап подготовки.
Детоксикация и снижение окислительного стресса (коррекция микробиоты, глутатион).
Купирование инфламейджинга (низкодозная терапия статинами, метформином или специфическими нутрицевтиками).
Проведение регенеративной процедуры (введение клеточного продукта).
Постпротокольная поддержка (пептиды, физическая реабилитация для стимуляции ангиогенеза).
Безопасность и долгосрочные риски
Обсуждение безопасности процедур — это зона повышенной ответственности anti-age врача.
Онконастороженность. Теоретически, любая стимуляция пролиферации несет риск активации неоплазий. МСК обладают сложным эффектом: с одной стороны, они подавляют рост некоторых опухолей (за счет иммуномодуляции), с другой — могут способствовать росту микрометастазов. Скрининг (онкомаркеры, МРТ всего тела, выявление недиагностированных новообразований) перед клеточной терапией — обязательное условие.
Иммуногенность. Повторные введения аллогенных МСК могут вызывать сенсибилизацию и снижение эффекта. Поэтому стратегия "одна инъекция раз в год" часто уступает месту комбинированным протоколам с использованием аутологичного PRP или экзосом.

Заключение
Подводя итог, можно утверждать, что инновационные методы регенерации тканей прочно вошли в арсенал антивозрастной медицины, однако их применение требует от врача не только энтузиазма, но и глубокого понимания молекулярной биологии.
Для успешной интеграции этих технологий в практику мы рекомендуем придерживаться следующих принципов.
Отказ от универсальности. Не существует одной "волшебной" клетки или экзосома на все случаи жизни. Выбор метода (МСК, экзосомы, матрикс) зависит от цели: фиброз vs. атрофия, локальная эстетика или системное старение.
Соблюдение регуляторных норм. Врач должен четко разделять протоколы, имеющие статус "медицинской услуги" (например, PRP терапия как аутологичный продукт), и экспериментальные методики, требующие отдельного информированного согласия.
Ориентация на доказательства. Необходимо требовать от поставщиков биоматериалов не только сертификаты, но и ссылки на клинические результаты, опубликованные в рецензируемых журналах.
Комплексный подход. Регенерация тканей должна быть частью целостной стратегии управления старением, включающей работу с метаболизмом, воспалением и эпигенетикой.
Антивозрастная медицина будущего — это не замена "изношенных деталей", а создание условий для самообновления организма. Задача врача — грамотно применять биорепаративные технологии, обеспечивая баланс между эффективностью и безопасностью.

Список использованной литературы:
López-Otín C., et al. Hallmarks of Aging: An Expanded Universe. Cell.- 2023
https://pubmed.ncbi.nlm.nih.gov/36599349/Galipeau J., Sensébé L. Mesenchymal Stromal Cells: Clinical Challenges and Therapeutic Opportunities // Cell Stem Cell.- 2024
https://pubmed.ncbi.nlm.nih.gov/29859173/KouM. et al. Mesenchymal stem cell-derived extracellular vesicles for immunomodulation and regeneration: a next generation therapeutic tool? // Cell Death Dis.- 2022
https://pubmed.ncbi.nlm.nih.gov/35787632/Amor C., et al. Prophylactic and long-lasting efficacy of senolytic CAR-T cells against age-related metabolic dysfunction // Nature Aging.- 2023
https://pubmed.ncbi.nlm.nih.gov/37841853/Horvath S., Raj K. Epigenetic clocks and their applications in clinical practice // Nature Reviews Genetics.- 2024
https://pubmed.ncbi.nlm.nih.gov/29643443/International Society for Stem Cell Research (ISSCR). Guidelines for Stem Cell Research and Clinical Translation.- 2024
https://www.isscr.org/guidelines





 Забрать бонусы в Телеграм
Забрать бонусы в Телеграм